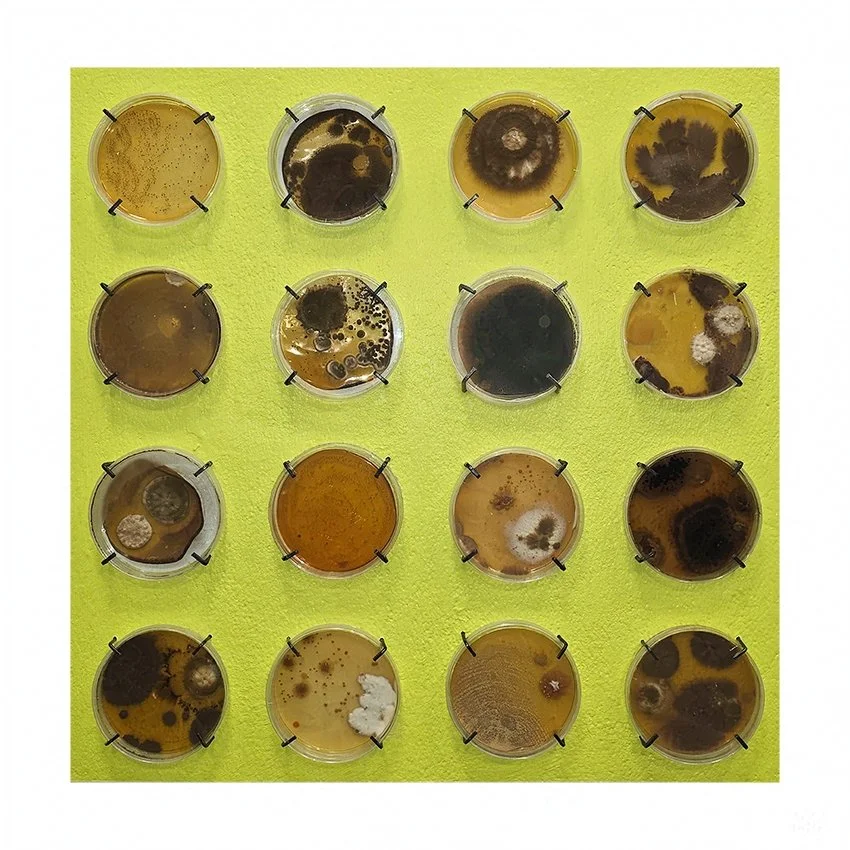

Erinnerung

Entmystifizierung geheiligten Fleisches
2024, Installation
Tuftteppich aus weißer und handgefärbter roter Schurwolle, Edelstahl-Schlachtschrage, Gelatineguss, abgetöteter und versiegelter Schimmel, Wildschweinfellvorleger, 600 x 600 x 350 cm
Eine raumgreifende Installation, in der Jagdtapisserie, Schlachthausästhetik und zerfallende Körperlichkeit ineinandergreifen. Rote Naturschurwolle durchschneidet elfenbeinfarbene Naturbelassene Wollfächen und Zeichnet so die Narration der Installation. Speckkäfer, deren gelatinekörper Spuren von Verfall tragen, kreisen rituell um ein geöffnetes, frischeres Gelatineschwein. Erinnerungsfragmente, familiäre Anekdoten und archaische Symbolik verknoten sich zu einem vielschichtigen Narrativ – zwischen Opfer, Ritual und der unstillbaren Suche nach Erfüllung.
Busóztató
2024, Performance und Kostüm
Verkleidung aus Gelatine, Zackelschaf Fell und Filz, Stoff, Metall, Geweih, Holz
Die Performance Busóztató wurzelt in einer Erinnerung, die niemand aus meiner Familie mit mir teilt. Weder meine Eltern noch Großeltern sind der Meinung, je mit mir einen Busó-Festzug besucht zu haben und das obwohl in mir ein diffuses, wohliges Gefühl bleibt, welches meine Realität, diesem wintervertreibenden Ritual als Kind begegnet zu sein, hält. In diesen Lücken wohnt der Busó, er ist. Ohne sich von menschlichen Geschehen beeinträchtigen zu lassen, verwandelt er den Raum in dem er erscheint in Ritual. Seine Gegenstände die er bei sich trägt vereinen Zeiten, in denen verschiedene, viele Generationen an Menschen gelebt, gedacht, erlebt, erinnert und gefühlt haben. Der Busó handelt auf seiner eigenen Zeitachse, eine Spanne in der 500 Jahre alte Glocken nicht so weit von Ganzfinger-Gliederringen entfernt sind. Sieht man diesen Busó, verabschiedet er sich bereits von einem. Erinnerung wird Körper, in Form einer archaische Präsenz, die dann so, wie auftaucht, uns wieder verlässt.
Nächste Arbeit
Mehr Inhalt...
Parallele Realitäten

Psychophysische Residuen
2025, Installation
Biologisch abbaubares, natürliches Verbundmaterial, Geruch Größe variabel
In dieser Arbeit habe ich das Netz der fünften Dimension - Prädestinationen geleitet von einem pulsierendes Geflecht aus Gerüchen - in unsere Realität gefaltet um diese entdeckte andere Realität mitzunehmen. Säulen, die dieser Anderen Realität entspringen sollten dieses Geflächt eigentlich tragen, doch sie hängen unmündig in Der Gerucharchitektur der fünften Dimension, als Residuen gescheiterten menschlichen Handelns. Geruch als interface, eine durchschreitbare Architektur, jede Bewegung, jeder Moment wird erfahrbar im Zusammenspiel von überlappenden Realitstrukturen und den multisinnlichen Artefakten. Die Arbeit fordert zur sensorischen Teilnahme auf.

Nantaimori – ein rosig, schmackhafter, doch haariger Schutzpatron
2020/2021, Installation
Digitaldruck auf PVC, Aluminiumplatte, Pannesamt, Silikon, pakistanisches Rosenöl
172,6 × 96,3 cm
Zwei christliche Bildtraditionen verbinden sich in dieser Installation: die Pelikan-Allegorie, die im Physiologus als Sinnbild für Hingabe und Fürsorge überliefert ist, und die Schutzmantelmadonna, die Geborgenheit und Schutz gewährt. In meiner Version verwandeln sich diese Gesten in hängende Fleischlappen und abstrahiertes Gedärm, die zugleich an Nahrung, Körper und Verletzlichkeit erinnern. Der Titel verweist auf 男体盛り – Nantaimori, das männliche Pendant zu Nyotaimori, bei dem Speisen auf nackten Körpern serviert werden. Hier begegnen sich Sakralität und Dekadenz, Fürsorge und Objektifizierung, Geben und Benutztwerden in einer einzigen Geste. Der Rosenduft des Silikon-Gedärms entfaltet sich im Raum, noch bevor das Werk überhaupt sichtbar wird. Hängt das Bild über einem Durchgang, durchläuft man die Fleischlappen vielleicht ohne es zu wissen – und empfängt dennoch ihren Schutz, ihren Segen. Es hängt nicht nur eine Ikone,, sondern eine Version meiner Selbst, die Handlungsmacht besitzt. Die Arbeit bin ich, und ich bin die Arbeit. Wir existieren gleichzeitig unabhängig voneinander, zwei sich überschneidende parallele Realitäten.

Aeaea Shrine
2018, Installation
PLA-3D-Kunststoff-Druck, Plexi-Acrylglas, Fäulnissäfte, Mehlwürmer
Der Sechs transluzente, 3D-gedruckte Schweinefüße sollten in Form von schifförmige Grabmäler angeordnet, in einem Meer aus Mehlfürmern stehen. Die vielen Mundwerkzeuge und Füßchen der Mehlwürmer erzeugen auditive Interferenzen, die auch haptisch im Inneren der Ohren wahrgenommen werden können. Dieser Moiré Effekt der Sound-Interferenzen entstehen durch Überlagerung von Geräuschwellen, Potenzierung dieser, oder Auscenceln. Kirke wird erfahrbar: ihre Fähigkeit, Menschen zu verwandeln, spiegelt sich in der unkontrollierbaren Bewegung des rezipierenden Trommelfells, Ihre Anziehungskraft in den Schweinefuß erklimmenden Mehlwürmern und Ihre Unabhängigkeit in dem Zustand dieser Installation wider. Digital modelliert, analog nachbearbeitet, PLA, Plexi, organische Substanzen und lebende Tiere. Die Grenze zwischen Natürlichkeit und künstlicher Form interferiert in mehreren meiner Arbeiten als Konzeption weiter. Diese Arbeit existiert auf einer anderen Ebene und begleitet mich auf meiner Odyssee.
Nächste Arbeit
Mehr Inhalt...
Transformation

Es bleiben nur Nadeln und Nägel
2023, Installation
Vielzahl von Materialien
Während des Wintersemesters 2022/2023 begann ich, meinen medialen Konsum, der seit der Coronazeit auf dem Zenit stand, auf Instagram, TikTok und Twitter bewusst zu reflektieren und den von Algorithmen zugespielten Content zu sammeln. Jedes Video, Foto oder Posting, das erfolgreich meine Aufmerksamkeit fesselte wurde in einem Ordner archiviert.
Aus dieser digitalen Sammlung von über 11.000 Dateien entstand diese mehrteilige Installation.
Die Serie, deren Individuelle Arbeiten Organe Bilden, die Zusammen als eine Installation lebendig werden, hinterfragen was aus unserer digitalen Welt als archäologische Spur bleibt, dokumentieren den menschlichen Versuch, Emotionen festzuhalten und hilft mir auf meinem Weg aus meiner gelebten, aktiver Zersetzung etwas Dauerhaftes, Unsterbliches zu ziehen.
Mycunculus
2023
Künster*innen-Schimmel in Kimmig-Petri-Schalen je Ø 8 cm
Mit Bedacht nehmen teilnehmende Künstler*innen auf der Haut ruhende Pilzsporen, von ihnen ausgewählter Körperstellen ab und tragen sie vorsichtig auf Agarplatten in Petrischalen auf. Jede Schale wird abschließend hermetisch versiegelt, in liebevoll vorbereiteten Bedingungen gelagert, damit die Kolonien ungestört wachsen können. Die Schönheit liegt in der scheinbaren Stille dieses Wachstums. Denn diese Kolonien machen sichtbar was sonst im Verborgenen bleibt. Sie erzählen vom Sein eines Individuums, von Begegnungen, die das eigene Leben formen, und von den unsichtbaren Spuren, die wir aufeinander hinterlassen. So entsteht ein zeitgenössisches Pendant zum Homunkulus aus Künstler*innen-Schimmel.

Rattenmätresse
2018, Plastik
PLA-3D-Kunststoff-Druck, verschiedene Farben und Größen
Diese 3D Drucke entstanden aus der Faszination für das Morbide im Alltäglichen. Tiefgefrorene Futterratten wurden post mortem in eine friedlich kuschelige Löffelchenstellung gebracht, die individuellen Körper verschmelzen zu einer plastischen Symbiose.
Ihr Blutkreislauf verschränkt analoges und digitales.
Die Rattenkataver wurden gescannt, in der Übersetzung Verlorenes digital ergänzt, novimaginiert gesculptet, im 3D-Druck realisiert und abschließend analog nachbearbeitet. So entsteht eine hybride Materialität, die das Natürliche mit dem Künstlichen vereint.
Mehr Inhalt...
Mehr Inhalt...